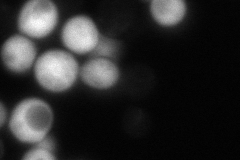
YIL094C

View description
Homo-isocitrate dehydrogenase, an NAD-linked mitochondrial enzyme required for the fourth step in the biosynthesis of lysine, in which homo-isocitrate is oxidatively decarboxylated to alpha-ketoadipate
Localization:
Intensity:
Fold change:
Significance:
-
C’ GFP library in SD

mitochondria230.98 -
N' NOP1pr-GFP in SD

mitochondria98.1762 -
N' TEF2pr-mCherry in SD

missing0 -
N' NATIVEpr-GFP in SD
below threshold15.9498 -
N' TEF2pr-VC and Cyto-VN in SD

#N/A0 -
C’ GFP library in SD+DTT

mitochondria310.571.34No -
C’ GFP library in SD+H2O2

mitochondria151.160.65No -
C’ GFP library in Starvation Media

mitochondria311.971.35No -
C’ GFP library on the background of Pup2-DaMP

mitochondria -
C’ GFP library on the background of CCT mutant

mitochondria275.8591.19428No
